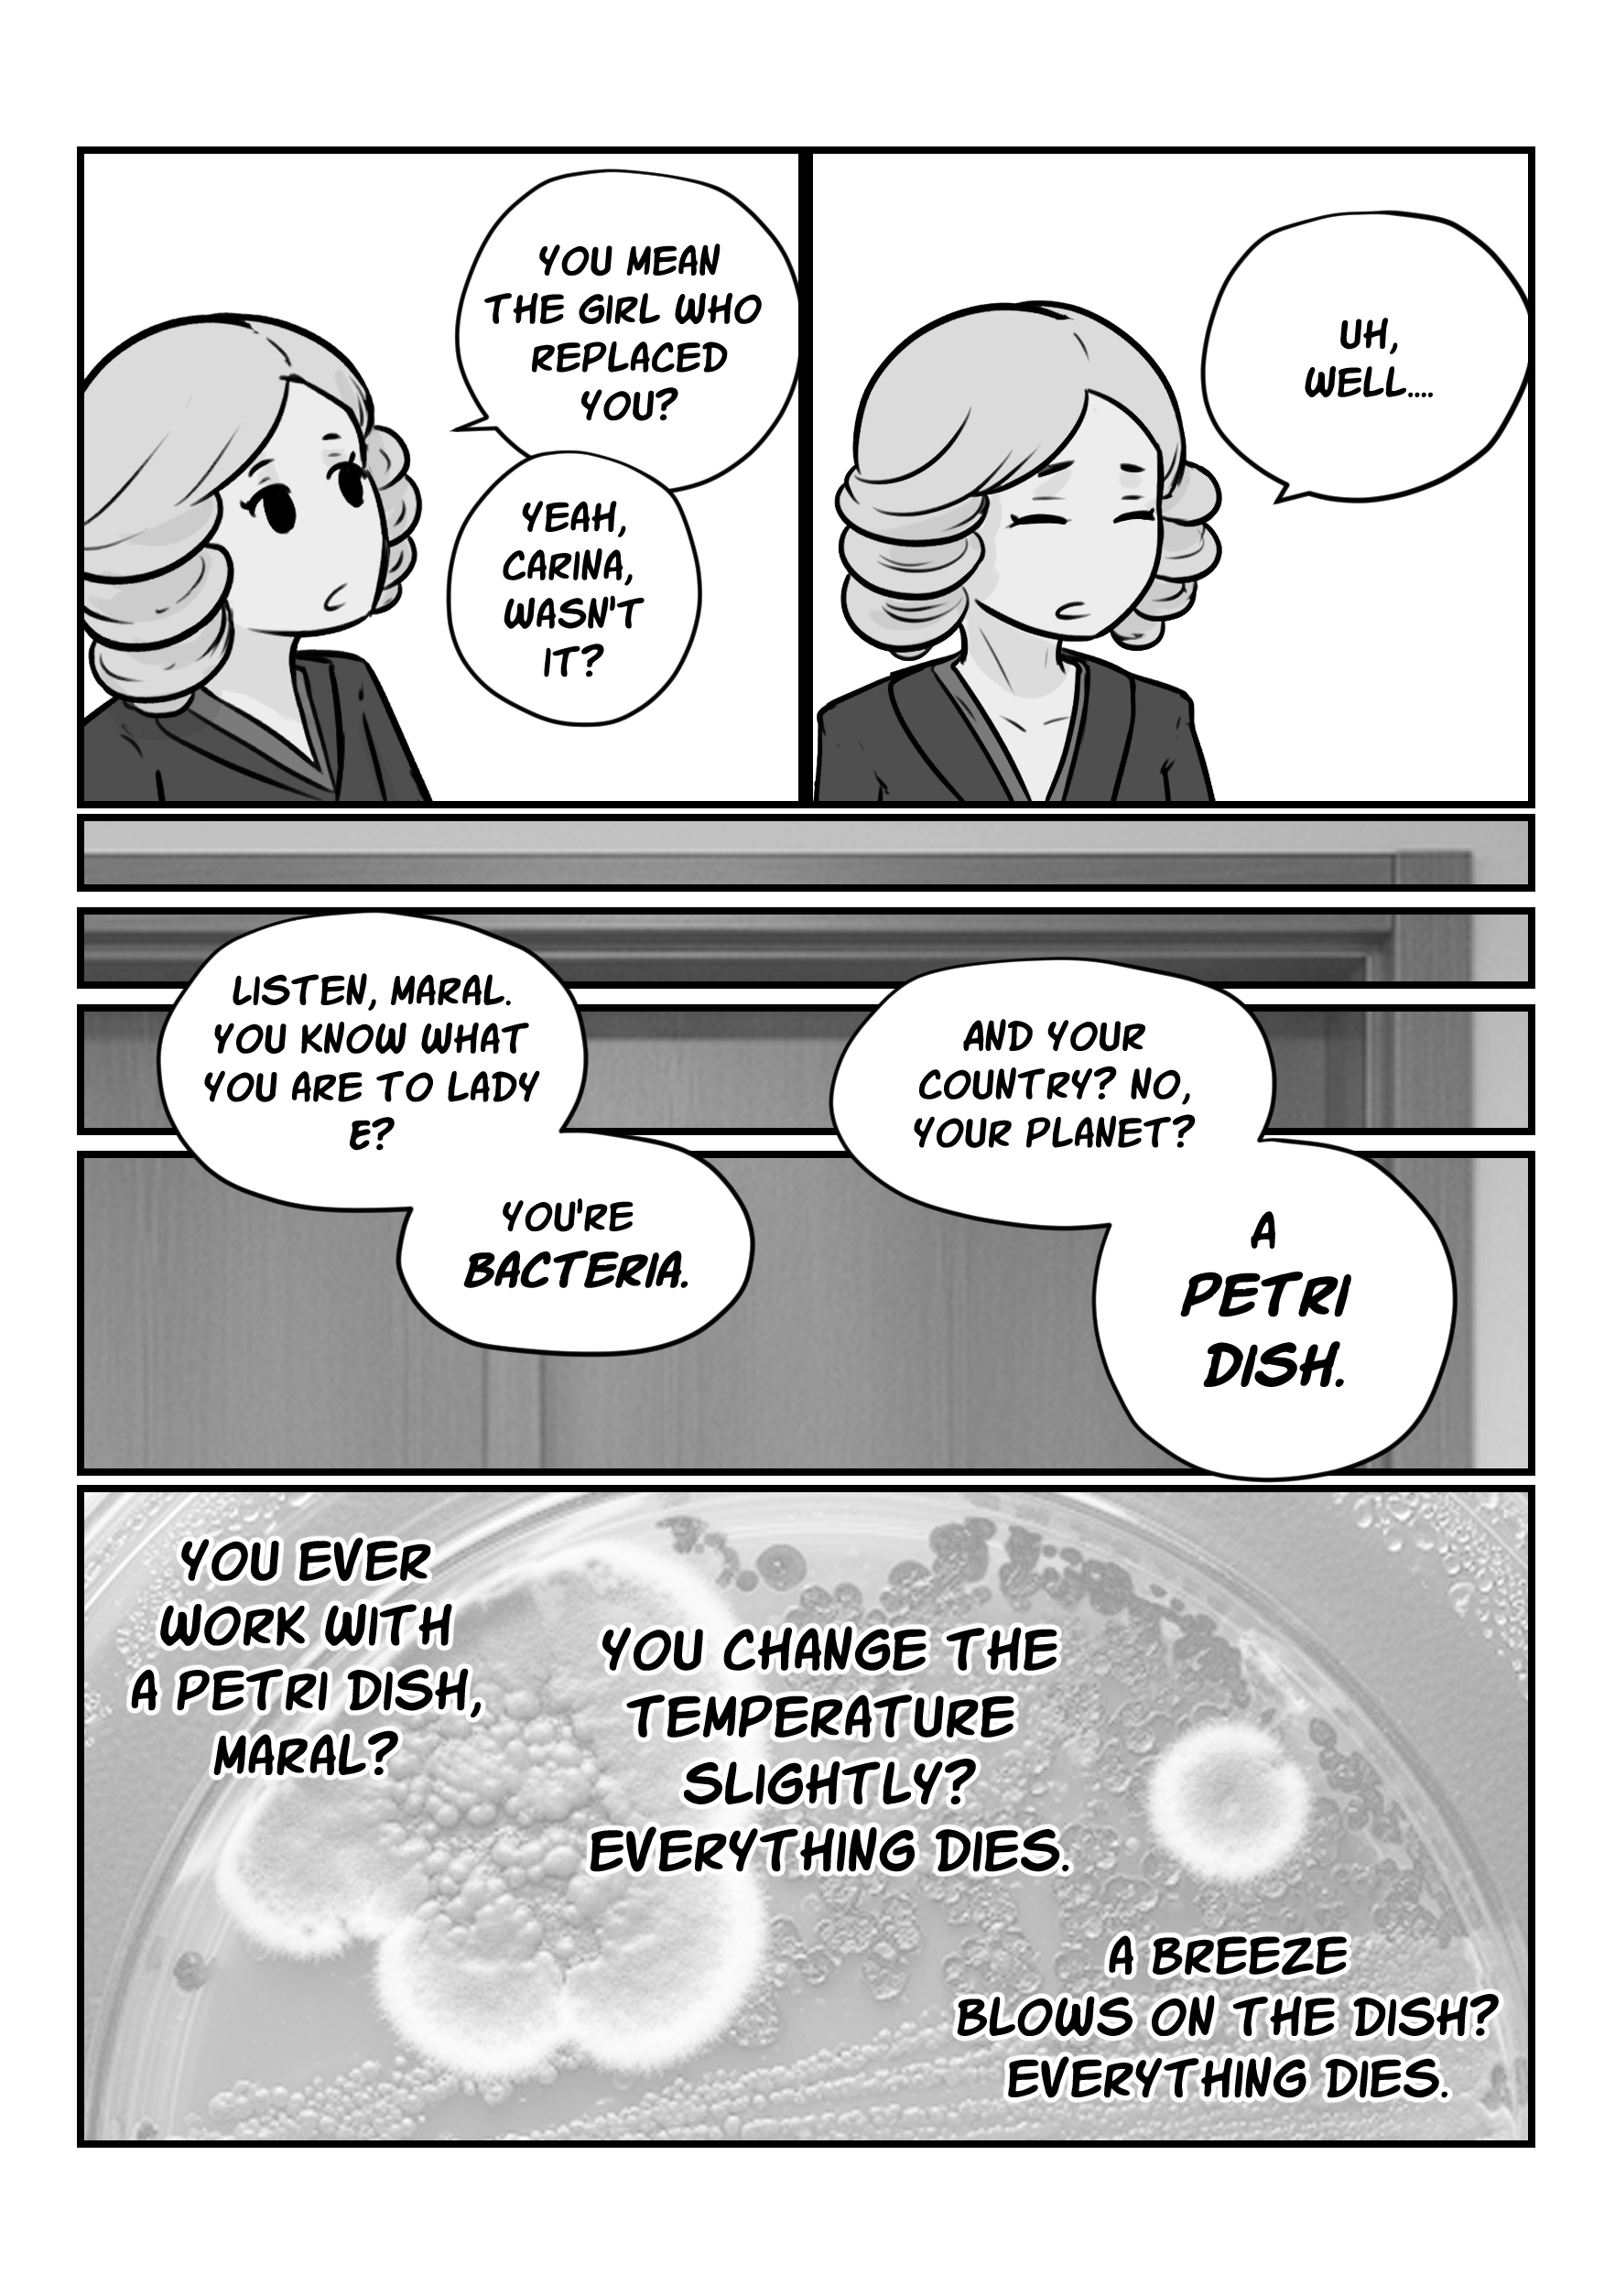
Page 3

One Piece
Eiichiro Oda
Page 1 / 20
Chapter 1 /
100